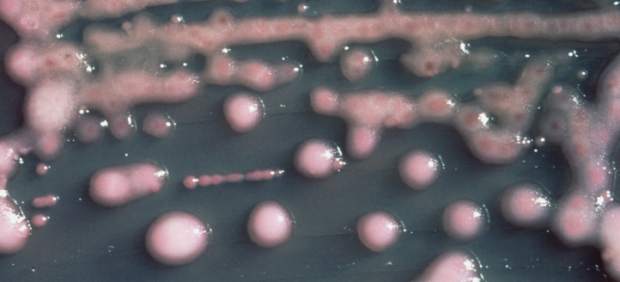
Bacteria

20MINUTOS.ES
- Se trata de un tipo de bacteria hospitalaria resistente ante los antibióticos más prevalentes.
- De los 13 contagiados, solamente cuatro han desarrollado infección.
La Consejería de Sanidad del Gobierno de Canarias, mediante el Servicio Canario de la Salud (SCS), está investigando los motivos de la transmisión de la bacteria hospitalaria 'Klebsiella pneumoniae OXA 48' a 13 personas de origen nórdico que estuvieron ingresadas en una clínica privada del sur de Gran Canaria. De todos ellos, solo cuatro han desarrollado infección.
Según la Consejería de Sanidad canaria, la 'Klebsiella pneumoniae' es un tipo de bacteria resistente a los antibióticos más prevalentes. Además, es una de las infecciones más frecuentes vinculadas con la asistencia sanitaria española.
Ha sido detectada en casi todas las comunidades autónomas del país, constituyendo un problema de salud pública prioritario que se enmarca en las líneas de vigilancia y control definidas por la Comisión Europea y el Centro Europeo de Control de Enfermedades (ECDC).
El Ejecutivo explicó que en cuanto los servicios de Salud Pública de Suecia y Noruega comunicaron al Ministerio de Sanidad, Consumo y Bienestar Social y SCS que sus pacientes habían dado positivo a esta bacteria hospitalaria, se inició un proceso de investigación con dichos servicios para conocer los casos concretos.
Pendiente de decretar el origen de la infección
Por su parte, el análisis genético de las cepas 'Klebsiella' aisladas de los pacientes de Suecia y Noruega muestra un origen común de la infección. Sin embargo, aún no han aportado la información epidemiológica de cada caso, necesaria para confirmar o descartar esta hipótesis principal.
No obstante, el ECDC decidió publicar la Evaluación Rápida del Riesgo sobre este evento aún sin disponer de resultados de las investigaciones en curso.
Tanto el Ministerio de Sanidad Consumo y Bienestar Social como las autoridades de salud pública de Canarias consideran que la información disponible en el momento de la publicación del documento por parte del ECDC no permitía apoyar de forma fiable las conclusiones del mismo y así se les comunicó.
source https://www.20minutos.es/noticia/3397354/0/sanidad-transmision-klebsiella-contagio-personas-canarias/
Comentarios
Publicar un comentario